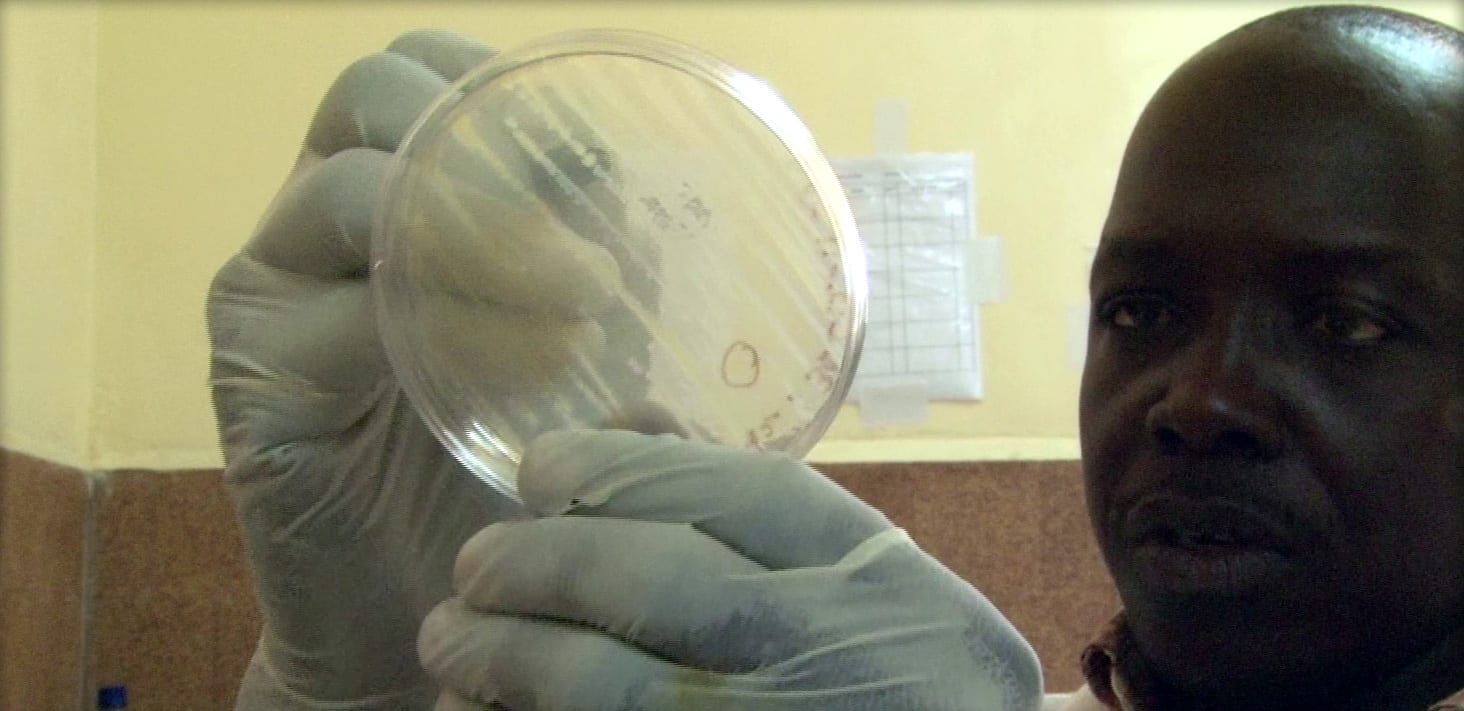

À la une
Témoignage de Namimou
Naminou Abakar est ingénieur au laboratoire de Farcha, au Tchad.
Au laboratoire Zootechnique du Tchad, l’agent technique d’ACF vient avec ses échantillons qu’il a prélevé sur le terrain, ensuite on inocule une colonie suspectée dans le milieu de conservation et cette bactérie positive va être acheminée jusqu’à l’Institut Pasteur à Paris.
Le choléra est endémique dans les pays du bassin du lac Tchad.
Mais c’est au Tchad que le vibrion est le plus virulent. En 2011, le pays a fait face à une épidémie sans précèdent : plus de 16 000 cas ont été enregistrés, dont 433 décès. Les mains sales, la consommation d’eau contaminée, de légumes crus, comme la salade et la tomate, favorisent l’expansion de la maladie.